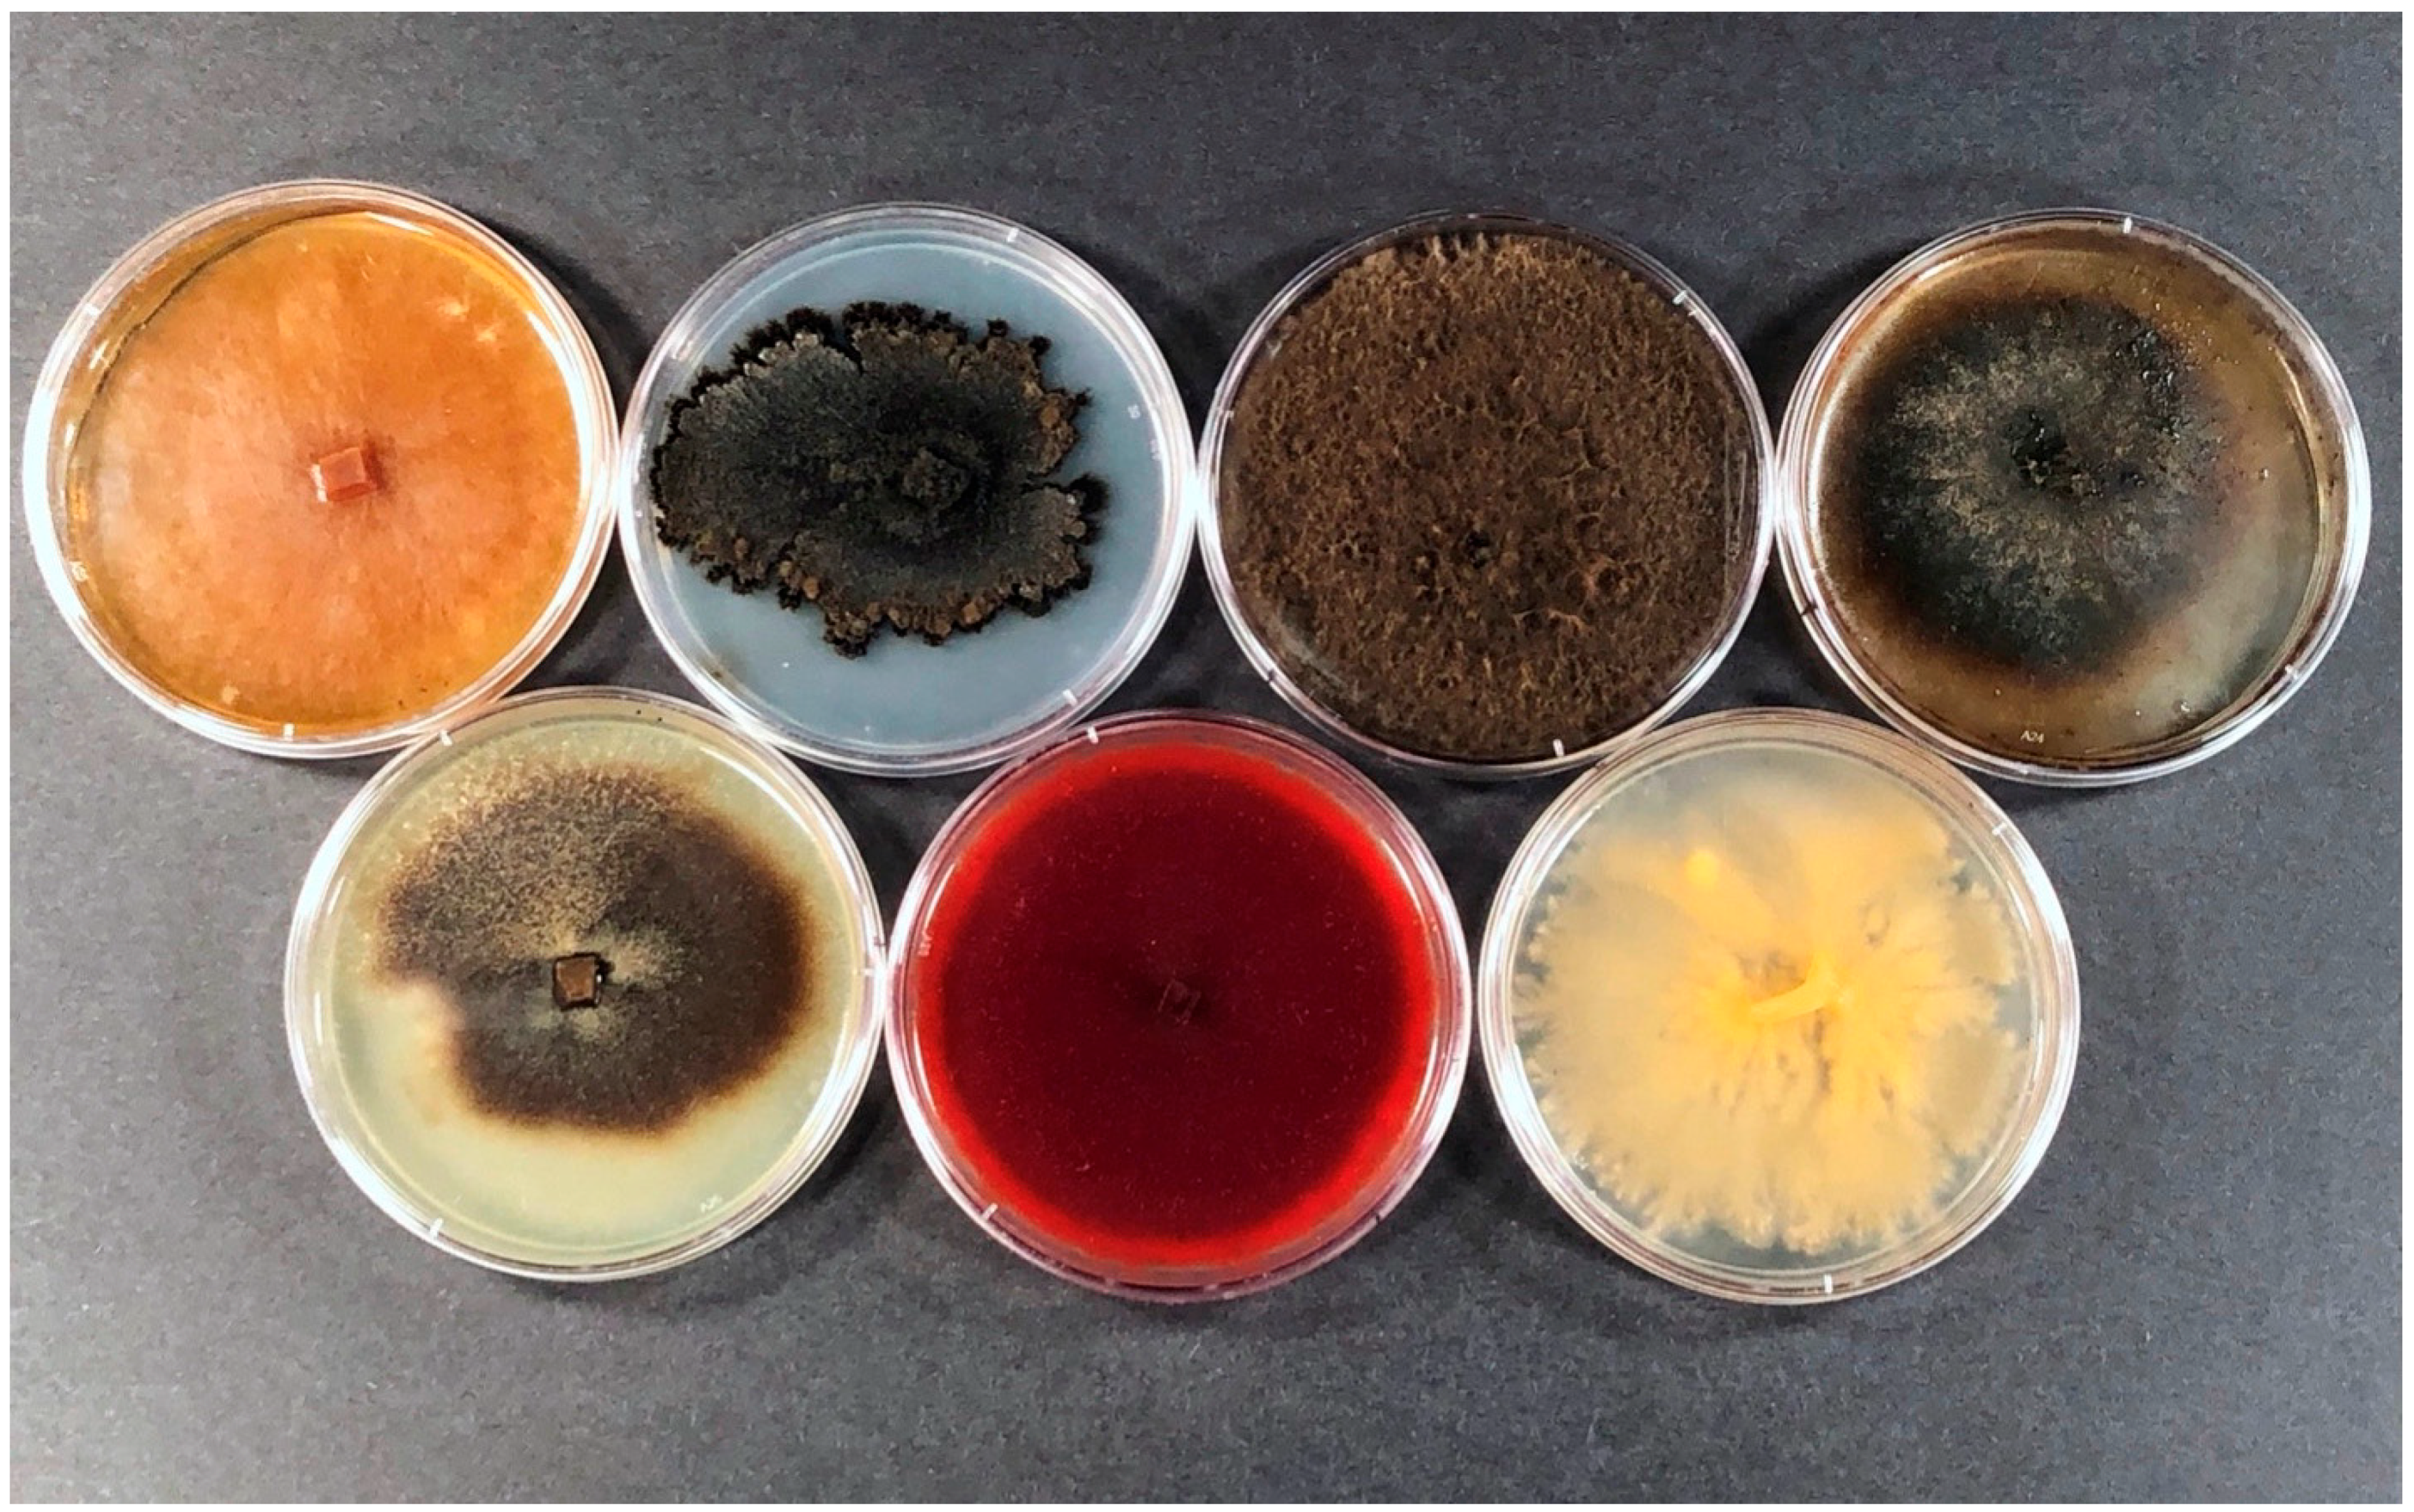

Fungi from Galleries of the Emerald Ash Borer Produce Cankers in Ash Trees
Abstract
:1. Introduction
2. Materials and Methods
2.1. Fungi Used for Inoculation
2.2. Field Trials
3. Results
3.1. Experiment 1
3.2. Experiment 2
4. Discussion
Author Contributions
Funding
Data Availability Statement
Acknowledgments
Conflicts of Interest
References
- Cappaert, D.; McCullough, D.G.; Poland, T.M.; Siegert, N.W. Emerald ash borer in North America: A research and regulatory challenge. Am. Entomol. 2005, 51, 152–165. [Google Scholar] [CrossRef] [Green Version]
- Herms, D.A.; McCullough, D.G. Emerald ash borer invasion of North America: History, biology, ecology, impacts, and management. Annu. Rev. Entomol. 2014, 59, 13–30. [Google Scholar] [CrossRef] [PubMed] [Green Version]
- Haack, R.A.; Baranchikov, Y.; Bauer, L.S.; Poland, T.M. Chapter 1: Emerald ash borer biology and invasion history. In Biology and Control of Emerald Ash Borer; USDA: Washington, DC, USA, 2015; pp. 1–14. [Google Scholar]
- United States Department of Agriculture. Available online: https://www.aphis.usda.gov/import_export/plants/manuals/domestic/downloads/eab-manual.pdf (accessed on 25 February 2021).
- Minnesota Department of Agriculture. Available online: https://www.mda.state.mn.us/minnesota-will-continue-emerald-ash-borer-regulations (accessed on 25 February 2021).
- Liu, H.; Bauer, L.S.; Miller, D.L.; Zhao, T.; Gao, R.; Song, L.; Luan, Q.; Jin, R.; Gao, C. Seasonal abundance of Agrilus planipennis (Coleoptera: Buprestidae) and its natural enemies Oobius agrili (Hymenoptera: Encyrtidae) and Tetrastichus planipennisi (Hymenoptera: Eulophidae) in China. Biol. Control 2007, 42, 61–71. [Google Scholar] [CrossRef]
- Liu, H.; Bauer, L.S.; Gao, R.; Zhao, T.; Petrice, T.R.; Haack, R.A. Exploratory survery for the emerald ash borer, Agrilus planipennis (Coleoptera: Buprestidae), and its natural enemies in China. Great Lakes Entomol. 2003, 36, 14. [Google Scholar]
- Cipollini, D. White fringetree as a novel larval host for emerald ash borer. J. Econ. Entomol. 2015, 108, 370–375. [Google Scholar] [CrossRef] [Green Version]
- Bauer, L.S.; Duan, J.J.; Gould, J.R. Chapter 17: Emerald ash borer (Agrilus planipennis Fairmaire) (Coleoptera: Buprestidae). In The Use of Classical Biological Control to Preserve Forests in North America; U.S. Department of Agriculture, Forest Service, Forest Health Technology Enterprise Team: Morgantown, VA, USA, 2014; pp. 189–209. [Google Scholar]
- Held, B.W.; Simeto, S.; Rajtar, N.N.; Cotton, A.J.; Showalter, D.N.; Bushley, K.E.; Blanchette, R.A. Fungi associated with galleries of the emerald ash borer. Fungal Biol. 2021, 125, 551–559. [Google Scholar] [CrossRef]
- O’Donnell, K.; Cigelnik, E. Two divergent intragenomic RDNA ITS2 types within a monophyletic lineage of the fungus Fusarium are onorthologous. Mol. Phylogenet. Evol. 1997, 7, 103–116. [Google Scholar] [CrossRef]
- Glass, N.L.; Donaldson, G.C. Development of primer sets designed for use with the PCR to amplify conserved genes from filamentous Ascomycetes. Appl. Environ. Microbiol. 1995, 61, 1323–1330. [Google Scholar] [CrossRef] [Green Version]
- Carbone, I.; Kohn, L.M. A method for designing primer sets for speciation studies in filamentous ascomycetes. Mycologia 1999, 91, 553–556. [Google Scholar] [CrossRef]
- Altschul, S.F.; Gish, W.; Miller, W.; Myers, E.W.; Lipman, D.J. Basic local alignment search tool. J. Mol. Biol. 1990, 215, 403–410. [Google Scholar] [CrossRef]
- Stauder, C.; Utano, N.; Kasson, M. Resolving host and species boundaries for perithecia-producing nectriaceous fungi across the Central Appalachian Mountains. Fungal Ecol. 2020, 47, 100980. [Google Scholar] [CrossRef]
- Zhou, X.; O’Donnell, K.; Aoki, T.; Smith, J.A.; Kasson, M.T.; Cao, Z.-M. Two novel Fusarium species that cause canker disease of prickly ash (Zanthoxylum bungeanum) in northern China form a novel clade with Fusarium torreyae. Mycologia 2016, 108, 668–681. [Google Scholar] [CrossRef] [Green Version]
- SAS v 9.4; SAS Institue Inc.: Cary, NC, USA, 2013.
- Kowalski, T.; Bilański, P.; Kraj, W. Pathogenicity of fungi associated with ash dieback towards Fraxinus excelsior. Plant Pathol. 2017, 66, 1228–1238. [Google Scholar] [CrossRef]
- Kraj, W.; Kowalski, T.; Zarek, M. Structure and genetic variation of Diplodia mutila on declining ashes (Fraxinus excelsior) in Poland. J. Plant Pathol. 2013, 95, 499–507. [Google Scholar] [CrossRef]
- Díaz, G.A.; Latorre, B.A.; Ferrada, E.; Gutiérrez, M.; Bravo, F.; Lolas, M. First report of Diplodia mutila causing branch dieback of English Walnut Cv. Chandler in the Maule Region, Chile. Plant Dis. 2018, 102, 1451. [Google Scholar] [CrossRef]
- Kepley, J.B.; Jacobi, W.R. Pathogenicity of Cytospora Fungi on six hardwood species. J. Arboric. 2000, 26, 326–333. [Google Scholar]
- Bush, E.A. Botryosphaeria Canker and Dieback of Trees and Shrubs in the Landscape. Available online: https://vtechworks.lib.vt.edu/bitstream/handle/10919/54993/450-726.pdf?sequence=1 (accessed on 25 February 2021).
- Feng, H.; Hong, K.; Xi, H.; Song, L.; Wen, C.; Zang, R. First report of branch canker on chinese date caused by Diplodia mutila in China. J. Plant Pathol. 2019, 101, 1251. [Google Scholar] [CrossRef] [Green Version]
- Brown-Rytlewski, D.E.; McManus, P.S. Virulence of Botryosphaeria dothidea and Botryosphaeria obtusa on apple and management of stem cankers with fungicides. Plant Dis. 2000, 84, 1031–1037. [Google Scholar] [CrossRef] [Green Version]
- Cloete, M.; Fourie, P.H.; Damm, U.; Crous, P.W.; Mostert, L. Fungi associated with die-back symptoms of apple and pear trees, a possible inoculum source of grapevine trunk disease pathogens. Phytopathol. Mediterr. 2011, 50, S176–S190. [Google Scholar]
- Kurbetli, İ.; Demirci, F. Outbreak of stem canker and dieback of pear trees caused by Botryosphaeria obtusa (anamorph Diplodia seriata) in Turkey. New Dis. Rep. 2014, 30, 6. [Google Scholar] [CrossRef] [Green Version]
- Verkley, G.J.M.; Silva, M.; Wicklow, D.T.; Crous, P.W. Paraconiothyrium, a new genus to accommodate the mycoparasite Coniothyrium minitans, anamorphs of Paraphaeosphaeria, and four new species. Stud. Mycol. 2004, 50, 323–335. [Google Scholar]
- Hausner, G.; Eyjólfsdóttir, G.G.; Reid, J.; Klassen, G.R. Two additional species of the genus Togninia. Can. J. Bot. 1992, 70, 724–734. [Google Scholar] [CrossRef]
- Mostert, L.; Groenewald, J.Z.; Summerbell, R.C.; Gams, W.; Crous, P.W. Taxonomy and pathology of Togninia (Diaporthales) and its Phaeoacremonium anamorphs. Stud. Mycol. 2006, 54, 1–113. [Google Scholar] [CrossRef] [Green Version]
- Eskalen, A.; Rooney-Latham, S.; Gubler, W.D. Occurrence of Togninia fraxinopennsylvanica on esca-diseased grapevines (Vitis vinifera) and declining ash trees (Fraxinus latifolia) in California. Plant Dis. 2005, 89, 528. [Google Scholar] [CrossRef]
- Bedker, P.; Blanchette, R. Development of cankers caused by Nectria cinnabarina on honey locusts after root pruning. Am. Phytopathol. Soc. 1983, 67, 1010–1013. [Google Scholar] [CrossRef]
- Grand, L.F.; Vernia, C.S.; Hodges, C.S. First report of Thyronectria austroamericana canker on thornless honey locust in North Carolina. Plant Dis. 1999, 83, 1177. [Google Scholar] [CrossRef]
- Jacobi, W.R.; Riffle, J.W. Effects of water stress on Thyronectria canker of honeylocusts. Phytopathology 1989, 79, 1333–1337. [Google Scholar] [CrossRef]

| Experiment 1 | Experiment 2 | |||
|---|---|---|---|---|
| Fungus | Agar Plug | Woodchip | Agar Plug | Woodchip |
| Control | 2/7 | 3/7 | 0/7 | 0/7 |
| Cytospora pruinosa (EAB 67-4) | 7/7 | 5/7 | 6/6 a | 6/6 a |
| Diplodia mutila (EAB 42-6) | 6/6 a | 6/6 a | 7/7 | 7/7 |
| Diplodia seriata (EAB 64-12) | 5/7 | 5/7 | 5/7 | 7/7 |
| Paraconiothyrium brasiliense (EAB 58-13) | 1/7 | 2/7 | 3/7 | 6/7 |
| Phaeoacremonium minimum (EAB 66-10) | 6/7 | 6/7 | 6/7 | 6/7 |
| Phaeoacremonium scolyti (EAB 64-22) | 4/7 | 6/7 | 4/6 a | 4/6 a |
| Thyronectria aurigera (EAB 45-20) | 4/7 | 6/7 | 6/7 | 6/7 |
| Agar Plug | Wood Chip | |||||
|---|---|---|---|---|---|---|
| Area (mm2) | Area (mm2) | |||||
| Fungus | Median | Interquartile Range | p-Value | Median | Interquartile Range | p-Value |
| Control | 0 | 0–16.5 | - | 0 | 0–15.5 | - |
| Cytospora pruinosa (EAB 67-4) | 169.2 | 48.5–218.8 | 0.04 | 63.9 | 0–82.5 | 0.2 |
| Diplodia mutila (EAB 42-6) | 270.8 | 86.4–507.3 | 0.02 | 141.6 | 37.9–176.9 | 0.03 |
| Diplodia seriata (EAB 64-12) | 36.5 | 0–93.3 | 0.2 | 34.8 | 0–85.8 | 0.25 |
| Paraconiothyrium brasiliense (EAB 58-13) | 0 | 0–0 | 0.6 | 0 | 0–37.5 | 0.77 |
| Phaeoacremonium minimum (EAB 66-10) | 23.9 | 13.2–36.4 | 0.12 | 24.8 | 15.6–64.7 | 0.11 |
| Phaeoacremonium scolyti (EAB 64-22) | 42.3 | 0–62.0 | 0.37 | 31.5 | 24.8–43.0 | 0.11 |
| Thyronectria aurigera (EAB 45-20) | 63.8 | 0–75.6 | 0.37 | 59 | 9.7–74.8 | 0.17 |
| Experiment 1 | Experiment 2 | |||||
|---|---|---|---|---|---|---|
| Fungus | Agar Plug | Woodchip | Percent Recovery (Agar Plug, Woodchip) | Agar Plug | Woodchip | Percent Recovery (Agar Plug, Woodchip) |
| Control | 0/7 | 0/7 | 0, 0 | 0/7 | 0/7 | 0, 0 |
| Cytospora pruinosa (EAB 67-4) | 5/7 | 4/7 | 71, 57 | 6/6 | 6/6 | 100, 100 |
| Diplodia mutila (EAB 42-6) | 6/6 | 6/6 | 100, 100 | 7/7 | 7/7 | 100, 100 |
| Diplodia seriata (EAB 64-12) | 6/7 | 7/7 | 86, 100 | 7/7 | 7/7 | 100, 100 |
| Paraconiothyrium Brasiliense (EAB 58-13) | 7/7 | 7/7 | 100, 100 | 6/7 | 6/7 | 86, 86 |
| Phaeoacremonium minimum (EAB 66-10) | 7/7 | 7/7 | 100, 100 | 5/7 | 6/7 | 71, 86 |
| Phaeoacremonium scolyti (EAB 64-22) | 5/7 | 6/7 | 71, 86 | 5/6 | 5/6 | 71, 71 |
| Thyronectria aurigera (EAB 45-20) | 0/7 | 0/7 | 0, 0 | 0/7 | 0/7 | 0, 0 |
| Agar Plug | Wood Chip | |||||
|---|---|---|---|---|---|---|
| Area (mm2) | Area (mm2) | |||||
| Fungus | Median | Interquartile Range | p-Value | Median | Interquartile Range | p-Value |
| Control | 0 | 0–0 | - | 0 | 0–0 | - |
| Cytospora pruinosa (EAB 67-4) | 72.6 | 38.5–121.6 | 0.008 | 74.4 | 70.5–96.0 | 0.008 |
| Diplodia mutila (EAB 42-6) | 341.9 | 101.0–928.1 | 0.006 | 323.5 | 233.2–402.5 | 0.006 |
| Diplodia seriata (EAB 64-12) | 69.9 | 0–77.4 | 0.03 | 74.5 | 63.3–99.8 | 0.006 |
| Paraconiothyrium brasiliense (EAB 58-13) | 0 | 0–29.8 | 0.1 | 59.2 | 27.3–70.0 | 0.01 |
| Phaeoacremonium minimum (EAB 66-10) | 35.8 | 30.4–50.9 | 0.01 | 32.6 | 21.0–107.5 | 0.01 |
| Phaeoacremonium scolyti (EAB 64-22) | 41.6 | 0–63.3 | 0.04 | 46.1 | 0–75.8 | 0.04 |
| Thyronectria aurigera (EAB 45-20) | 38.2 | 10.9–74.3 | 0.01 | 46.1 | 18.9–52.8 | 0.01 |
Publisher’s Note: MDPI stays neutral with regard to jurisdictional claims in published maps and institutional affiliations. |
© 2021 by the authors. Licensee MDPI, Basel, Switzerland. This article is an open access article distributed under the terms and conditions of the Creative Commons Attribution (CC BY) license (https://creativecommons.org/licenses/by/4.0/).
Share and Cite
Rajtar, N.N.; Held, B.W.; Blanchette, R.A. Fungi from Galleries of the Emerald Ash Borer Produce Cankers in Ash Trees. Forests 2021, 12, 1509. https://doi.org/10.3390/f12111509
Rajtar NN, Held BW, Blanchette RA. Fungi from Galleries of the Emerald Ash Borer Produce Cankers in Ash Trees. Forests. 2021; 12(11):1509. https://doi.org/10.3390/f12111509
Chicago/Turabian StyleRajtar, Nickolas N., Benjamin W. Held, and Robert A. Blanchette. 2021. "Fungi from Galleries of the Emerald Ash Borer Produce Cankers in Ash Trees" Forests 12, no. 11: 1509. https://doi.org/10.3390/f12111509
APA StyleRajtar, N. N., Held, B. W., & Blanchette, R. A. (2021). Fungi from Galleries of the Emerald Ash Borer Produce Cankers in Ash Trees. Forests, 12(11), 1509. https://doi.org/10.3390/f12111509

